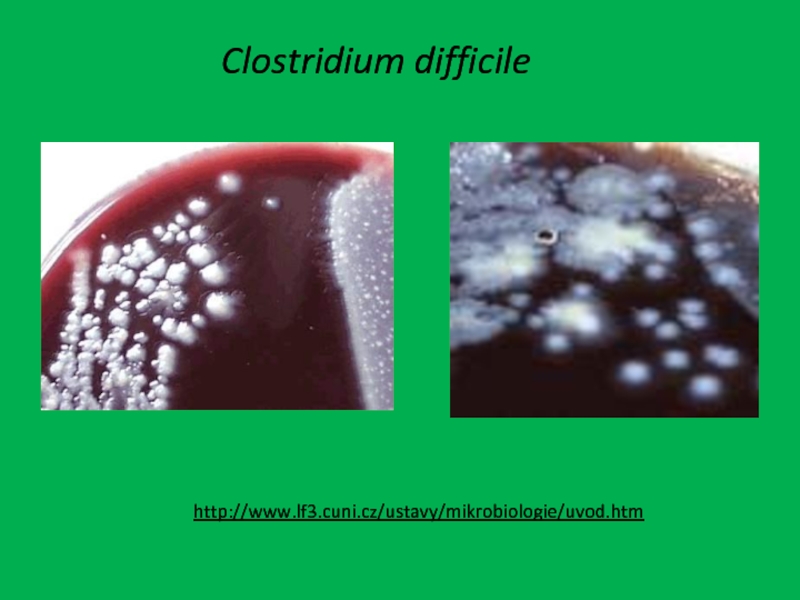

Разделы презентаций
- Разное
- Английский язык
- Астрономия
- Алгебра
- Биология
- География
- Геометрия
- Детские презентации
- Информатика
- История
- Литература
- Математика
- Медицина
- Менеджмент
- Музыка
- МХК
- Немецкий язык
- ОБЖ
- Обществознание
- Окружающий мир
- Педагогика
- Русский язык
- Технология
- Физика
- Философия
- Химия
- Шаблоны, картинки для презентаций
- Экология
- Экономика
- Юриспруденция
Псевдомембранозный колит
Содержание
- 1. Псевдомембранозный колит
- 2. Пути развития инфекции, вызванной Clostridium difficile
- 3. Слайд 3
- 4. C.difficilehttp://images.google.ru/imgres?imgurl=http://distans.livstek.lth.se:2080/Cl-1-07.JPG&imgrefurl=http://distans.livstek.lth.se:2080/C_difficile.htm&h=225&w=300&sz=31&tbnid=6e5XJARdZNXdQM:&tbnh=83&tbnw=111&hl=ru&start=20&prev=/images%3Fq%3DClostridium%2Bdifficile%26svnum%3D10%26hl%3Dru%26lr%3D%26sa%3DG
- 5. Clostridium difficile http://www.nlm.nih.gov/medlineplus/spanish/ency/images/ency/fullsize/1051.jpg
- 6. Clostridium difficile http://www.lf3.cuni.cz/ustavy/mikrobiologie/uvod.htm
- 7. Токсины C.difficileЭнтеротоксин или токсин АЦитотоксин или токсин ВТоксин, повышающий сократительную активность мускулатуры толстого кишечника
- 8. Частота выделения C.difficileВ.А. Малов. Антибиотикоассоциированные диареи. Клиническая микробиология и антимикробная химиотерапия. №1, 2002
- 9. Патогенез развития псевдомембранозного колита
- 10. Псевдомембранозный колитhttp://www.health.am/ab/more/early-intervention-by-infectious-diseases/http://www.sharinginhealth.ca/pathogens/bacteria/clostridium_difficile.html
- 11. http://www.examiner.com/slideshow/c-diff#slide=1
- 12. Спасибо за внимание!
- 13. Скачать презентанцию
Пути развития инфекции, вызванной Clostridium difficile